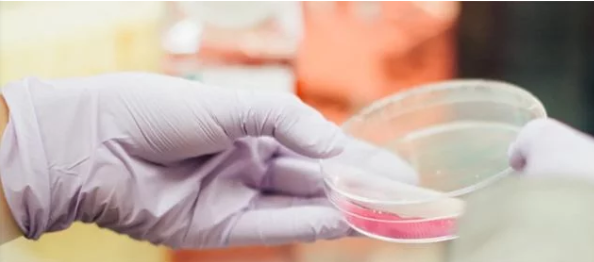

應(yīng)用
二氧化碳培養(yǎng)箱zui常用于醫(yī)學(xué)研究和制藥行業(yè)。但是,它們也為在其他必須在完全無菌環(huán)境中生長的細胞的*域提供了無菌條件。

在組織工程產(chǎn)品開發(fā)中如何使用CO 2培養(yǎng)箱的三個例子:
然后,人類胚胎開始在CO2培養(yǎng)箱中受精和發(fā)育,然后在兩到三天后移植到子宮中。培養(yǎng)箱中的zui佳條件約為37°C,5或6 vol。%CO2,濕度約95%。
工作人員非常精確地在培養(yǎng)皿上貼上標(biāo)簽,以免混淆。CO2培養(yǎng)箱的內(nèi)部玻璃門意味著可以隨時監(jiān)控碗碟。
在獸醫(yī)學(xué)中,例如與牛的過程相似。將卵母細胞與精子一起放入培養(yǎng)皿中,在21小時的潛伏期中,精子使它們受精。受精后第八天,將胚從CO2培養(yǎng)箱轉(zhuǎn)移到受體動物中。
CO2培養(yǎng)箱是涉及各種過程步驟的正確工具,例如解凍和轉(zhuǎn)移細胞,以及感染細胞系和染色細胞培養(yǎng)物。在此應(yīng)用過程中,內(nèi)部條件通常設(shè)置為37°C和5 vol。%CO2。
zui遲在72小時后分析樣品。細胞層的藍色使得可以用肉眼或在顯微鏡下更詳細地表征斑塊。
BINDER CO2培養(yǎng)箱特別適合用于診斷或病毒鑒定,因為它們保持極其穩(wěn)定的培養(yǎng)條件。內(nèi)部玻璃門也可用于分段訪問。此外,得益于180°C的自動熱風(fēng)滅菌,始終可以可靠地消除交叉污染和污染無聲蔓延的風(fēng)險。
可能的生物敏感性元素:
結(jié)合傳感器的細胞體外系統(tǒng)被用于制藥業(yè),毒理學(xué)和基礎(chǔ)研究。zui著名的例子之一是用于測量葡萄糖的酶傳感器。
一個令人印象深刻的例子:胚胎母雞的心肌細胞在旋轉(zhuǎn)培養(yǎng)中重新聚集成球體(3D結(jié)構(gòu))并連接到微電極。參考物質(zhì)被用來測試關(guān)于對生活系統(tǒng)施加刺激的陳述的程度。球狀體在37°C,5體積的CO2培養(yǎng)箱中的培養(yǎng)皿中生產(chǎn)。%CO2和72的轉(zhuǎn)速和20mm軌道。
正如美G癌癥研究協(xié)會(AACR18)在2017年如此強調(diào)地指出的那樣,在癌癥研究*域已經(jīng)取得了巨大進步。
CO2培養(yǎng)箱在癌癥研究的所有*域(例如藥物研究以及3D入侵,測定法和生物傳感器的開發(fā))中的樣品和測試制備中都發(fā)揮著重要作用-從簡單的單層到通過3D細胞復(fù)制患者腫瘤文化模型(藥物研究和開發(fā)方法)。
在免疫學(xué)和腫瘤生物學(xué)*域(惡性腫瘤如何發(fā)展),CO2培養(yǎng)箱的使用溫度為37°C,5 vol。%CO2和95%相對濕度含氧量正常條件下,以及CO 2 / O 2培養(yǎng)箱在37℃,5體積。%CO2和低氧1 vol。%O 2,取決于所涉及的細胞培養(yǎng)物。
在臨床研究中,例如,在致癌基因和腫瘤抑制因子方面,CO2培養(yǎng)箱的使用溫度為37°C和5 vol。常氧條件下的%CO2 。美G癌癥研究協(xié)會(AACR)的任務(wù)是通過研究,繼續(xù)教育,溝通與合作來預(yù)防和治療癌癥。
